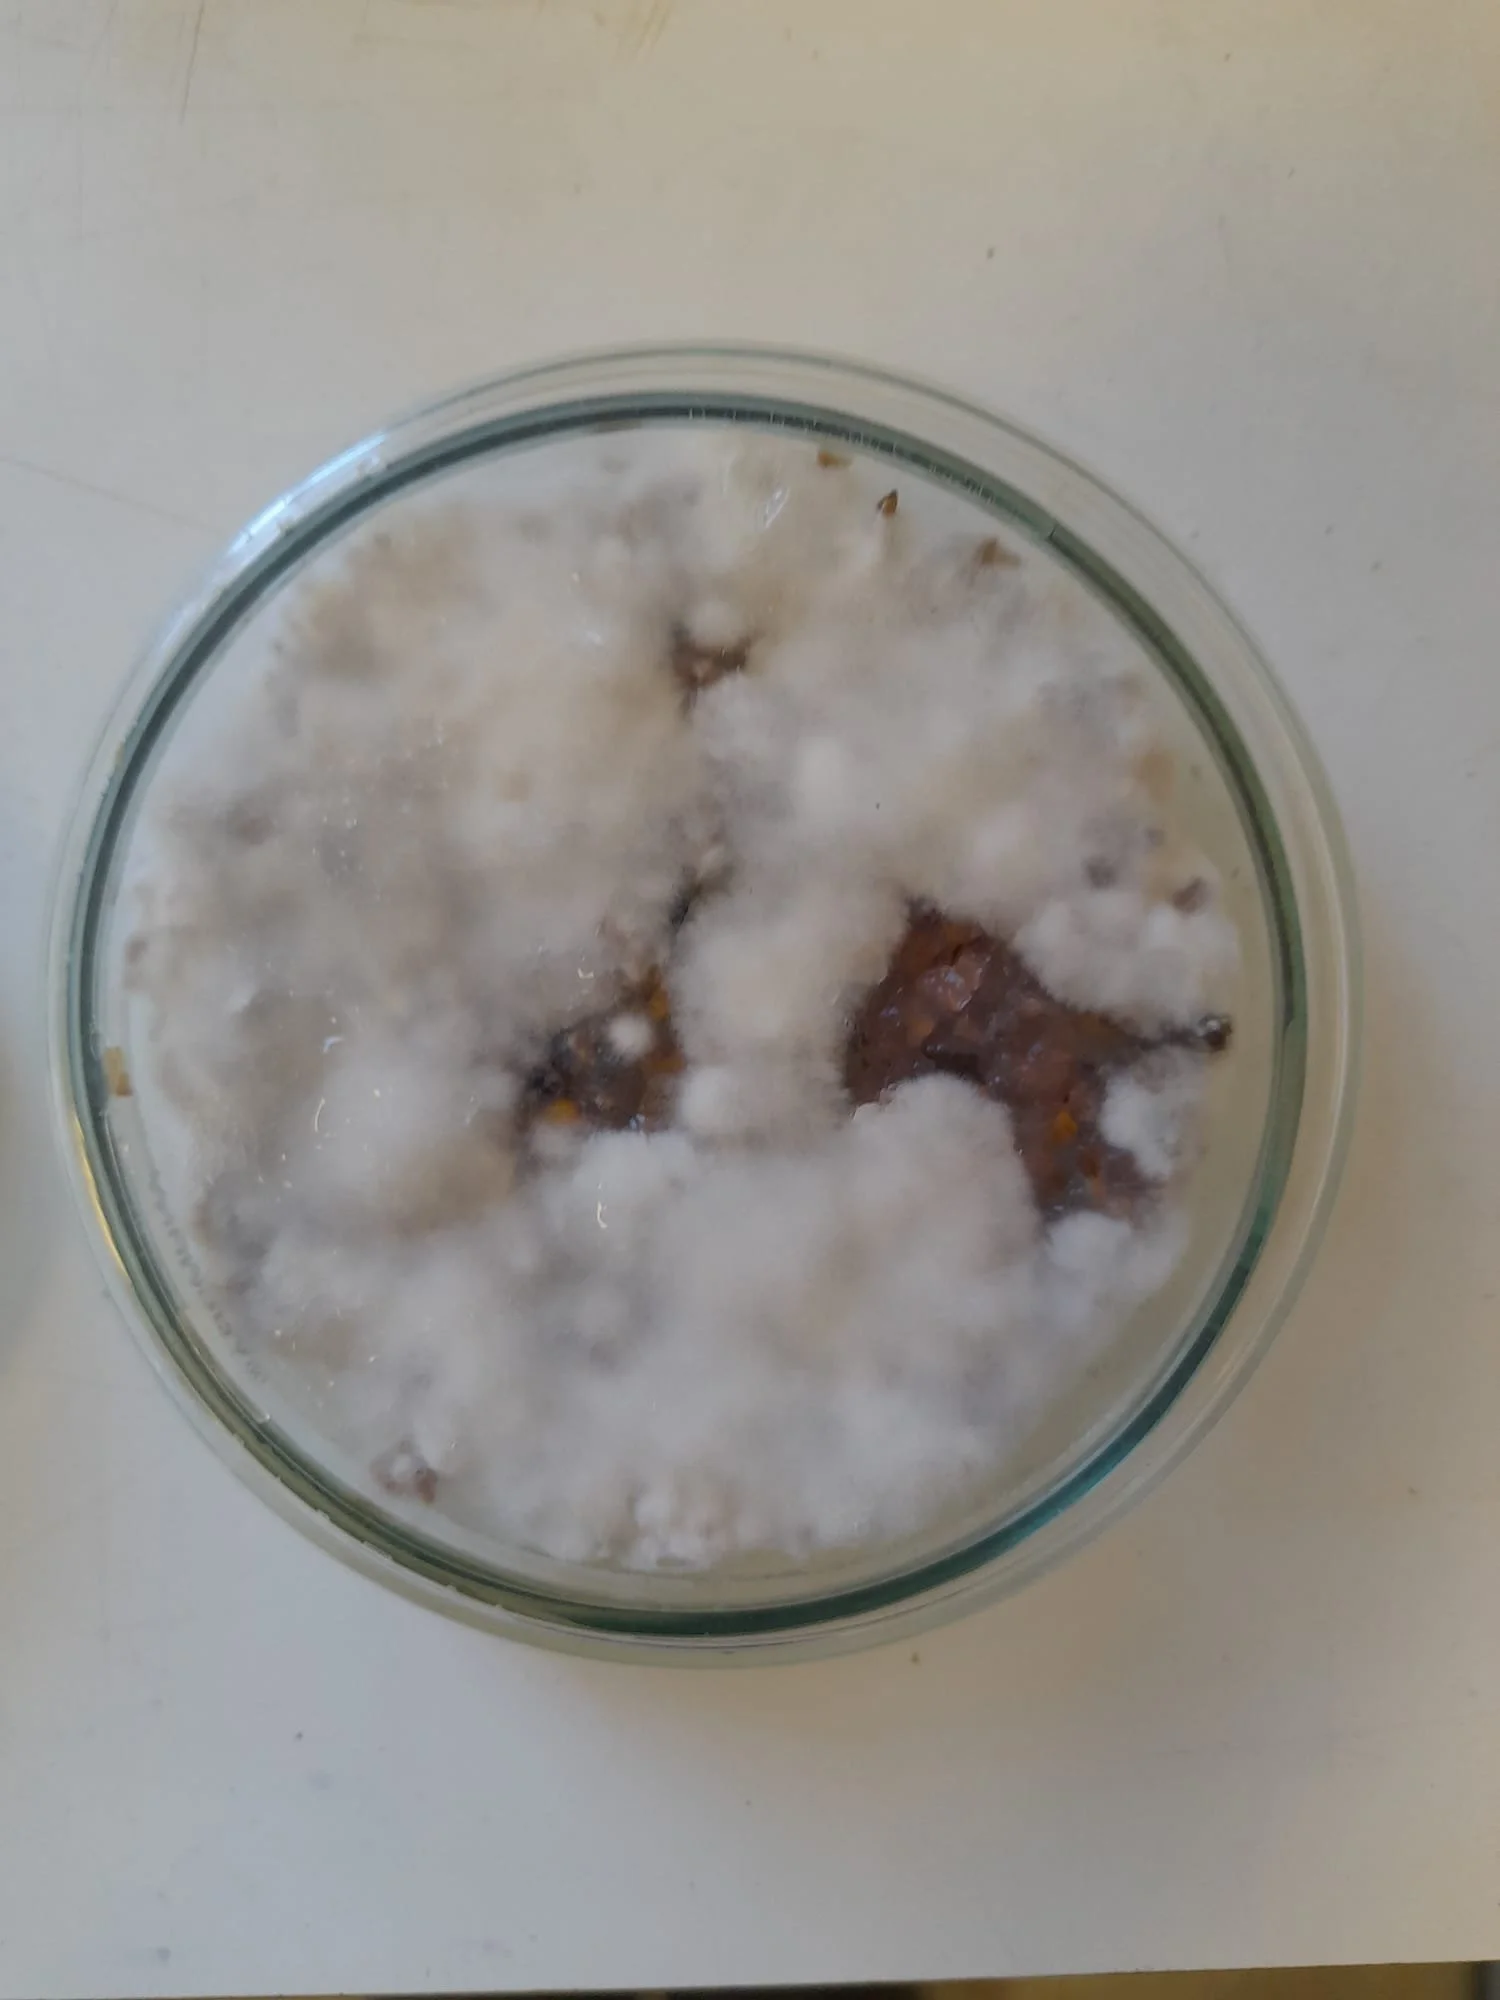

2024 Highlights
As we wrap up the 2024 year, we hope you enjoy reading about some of our highlights from the incredible projects, events and programmes we’ve put on and been a part of this year.
ASCUS Lab
This year finally felt like we could start bringing back more pre-covid elements to our operations despite still operating at a very limited capacity. We had 2 beginners microscopy courses this year and launched our evening sessions which take place on the 1st and 3rd Thursday of each month. Both these events will continue in 2025 so keep an eye on our mailing list, social media and what's on pages.
Participants from our Autumn Beginners microscopy course.
As always, we have been blown away by some of the work our lab users have been doing in the ASCUS Lab this year. Below is just a small showcase of some of the work that's taken place over the course of this year.
Genescapes-Scott Hunter
Our year hit the ground running with the project Genescapes by multidisciplinary artist, Scott Hunter. The incorrect disposal of chemicals used in the photography industry poses a significant threat to the environment, leading to silver contamination of water sources and subsequent harm to aquatic life. Genescapes aims to prevent such pollution by improving plants' natural silver accumulation abilities. Scott started his lab research and experimentation with genetically modifying bacteria, as a means to introduce a selected plant species with a metal tolerance gene. The methods and results of this lab-based research informed some creative outputs including a library of evaporated substances and imagery of plants under the microscope.
Image ©Scott Hunter
Above images ©Scott Hunter
Biotech start-ups
We have 2 biotech start-ups that are based at ASCUS and are proud of their achievements this year!
Cexal Ltd has been working at ASCUS since 2023 on new technology that detects biomarkers and bacteria in less than 30 minutes. This year saw them showcasing their first products, FluoCDx, a 25-minute bacterial phenotyping test, and RapidPath, a 25-minute bacterial genotyping test, as part of the Innovate UK GBIP program to fight against Antimicrobial Resistance.
Image ©Cexal Ltd
Algacraft was selected as part of London North Eastern Railway’s (LNER) flagship accelerator programme, FutureLabs, designed to bring new innovative concepts to the rail industry to address key challenges. Algacraft’s pilot project aimed to prove that microalgae can be successfully grown outdoors in the UK climate without the need for temperature control, and that the system was able to capture carbon on a small scale. The success of this pilot has led to them entering a second phase of testing with LNER.
Image ©LNER
Other Artists
As a reminder - ASCUS is a non profit organisation and we do our best to keep lab prices and events affordable. Donations are much appreciated and help us achieve this goal. We are also happy to tailor workshops and events to your needs and budget, so if you have an idea-we’d love to hear about it!
Unearthing Microlife Young People’s Programme
Unearthing Micro Life is an art-science creative learning programme, designed for teens or adults who may be socially isolated, find traditional learning environments challenging, or don’t have access to extracurricular programmes to enhance skill development. This programme aims to enable participants to engage creatively with their local greenspaces through outdoor interaction and sample collection, supported by hands-on experimentation in the ASCUS Lab.
This year's programme was delivered together with Edinburgh and Lothians Greenspace Trust (ELGT) and Child and Adolescent Mental Health Service (CAMHS). We explored a new site this year- Hermitage of Braid and Blackford Hill Nature Reserve. While we haven’t had a chance to write about this year's programme, you can get a gist of what this programme is all about from our post from last year's programme.
Surface Echoes
Surface Echoes is a collaborative project co-led by academic dermatologist and researcher, Prof. Sara Brown, and artist Beverley Hood that is aiming to amplify the voices of people living with eczema.
2024 included running some events with people that have a lived experience of eczema to test artwork ideas and refine the creative output which has taken the form of a collage and script. It’s currently in the final stages and we can’t wait for next year to see the complete version. Read more about this project and updates below.
Offsite Events
In February we were invited to co-deliver a workshop with artist Louise Mackenzie at the Centre for Contemporary Arts in Glasgow as part of artist Rae-Yen Song’s exhibition life bestowing cadaverous soooooooooooooooooooot. Together with Louise, we touched on the making of kombucha leather, algae and mycelium biomaterials. We also had some ASCUS-made artwork in the exhibition including our mycelium plant pot and agar-bacterial biomaterials.
Later in the year we ventured across the border to Berwick-upon-Tweed with Connecting Threads: Tweed River Culture to join a river clean event with our smartphone microscopes and other science-y things to get a qualitative idea of the river health.
We also teamed up with lab users, Algacraft, in a microscopy popup event at Edinburgh Waverley with LNER looking at algae under microscopes to shed some light on Algacraft’s innovative work using algae to capture carbon.
Edinburgh Science Festival
Together with Summerhall as part of the 2024 Edinburgh Science Festival, we launched our visual arts program, Future Proof, a series of exhibitions and events from visual artists that explore alternative futures through examination of the past and present and pose existential questions from the blurred boundary of art and science.
Featured exhibitions included Post Industrial Ecologies by Dawn Felicia Knox which explored the way plants and fungi work together to undo the toxic residue of industrialisation, A Topography of MicroPlanets by Imogen Hero which combined expertise in analogue photographic techniques with scientific processes to examine the interconnectedness of life in the Universe, Morality Calculus by artist Yuning Chen recounted the endeavour of creating bread fermented with yeast-human cell hybrids in a synthetic biology lab in collaboration with biologist Dr. Elise Cachat, and others which you can find out more about below.
We were also commissioned by Edinburgh Science to make an algae biomaterial exhibit for the National Museum of Scotland's Growing Home.
If you’ve made it this far - thank you for reading!
We hope you all have a fantastic festive season. We'll see you in 2025 where our calendar is already filling up fast!